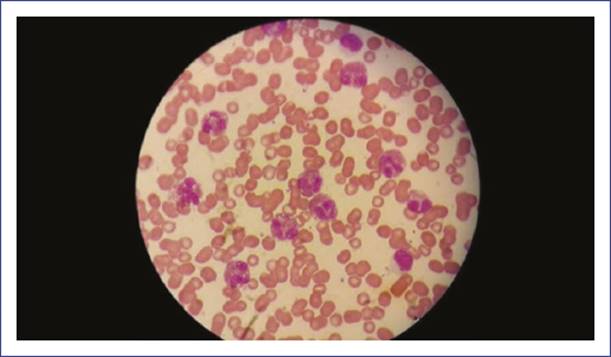

Introduction
The hypereosinophilic syndrome (HES) is defined by the presence of an eosinophilic count > 1500 cell/mm3 with organ damage or dysfunction without any underlying cause, which can be easily mistaken for atopic dermatitis or pulmonary pathologies. Early diagnosis and treatment can improve the prognosis and avoid heart and renal complications or lung fibrosis1.
Case report
A male infant of 1 year and 5 months of age was admitted to the emergency room with a 7-day history of fever, pharyngitis, and generalized dermatosis that affected palms and soles of the feet with no prior medication (Fig. 1). With a complete immunization schedule, a personal history of atopic dermatitis for 1 year of age with inadequate response to conventional treatment was registered.
Complete blood count (CBC) showed 18,900 mm3 leukocytes, 36% neutrophils, 12% lymphocytes, 17% eosinophils (3213 cell/mm3), and 23% immature neutrophils. The hypereosinophilia was attributed to the severe atopic dermatitis, for which a course of antibiotics for supposed erysipelas was started. No response to treatment was observed after 3 days. Subsequently, the infant was diagnosed with incomplete Kawasaki disease and received a single dose of gamma globulin and daily steroids. He was discharged 7 days later with a satisfactory evolution.
Two months after, the patient was readmitted with a 24-h history of emetic cough and fever. No history of premedication or use of antibiotics or nonsteroidal anti-inflammatory drugs was registered. Signs were as follows: blood pressure 106/64 mmHg, heart rate 144/min, respiratory rate 32/min, oxygen saturation 92%, temperature 37.8°C, capillary refill time of 2 s, weight 10.8 kg, and height 81 cm. The physical examination revealed bilateral anterior and posterior cervical, occipital, inguinal, and axillary lymphadenopathies no larger than 1 cm of soft consistency. Furthermore, the patient showed respiratory distress, polypnea, and hypoventilation in both pulmonary bases and transmitted rales. No heart murmur or visceromegaly was observed.
Initially, the patient was treated for an airway infection, managing respiratory distress with salbutamol and ipratropium bromide. Due to the lymphadenopathies and fever, a chest X-ray was performed, which revealed pulmonary hyperinflation (Fig. 2).
CBC showed 43,900 mm3 leukocytes, 12.7% neutrophils, 11.7% lymphocytes, 2.4% monocytes, 68.8% eosinophils (30,203 mm3), 2% immature neutrophils, 13.4 g/dl hemoglobin, 37.5% hematocrit, and 215,000 platelets (Fig. 3).
To confirm HES diagnosis, additional tests were performed with the following results: immunoglobulins [IgA, 66.5 mg/dl (reference range (rr) 70-400 mg/dl); IgG, 1930 mg/dl (rr 700-1600 mg/dl); IgE, 1598.9 mg/dl (rr 0-100 mg/dl); IgM, 133 mg/dl (rr 40-230 mg/dl)], complements: C3, 104 mg/dl (rr 100-180 mg/dl) and C4, 19.7 mg/dl (rr 16-40 mg/dl), vitamin B12, 1078 pg/ml (rr 200-1000 pg/ml), and tryptase, < 0.2 U/l (rr < 2 U/l). The coproparasitoscopic results were negative, and both renal and liver functions were normal, as well as serum electrolytes.
Bone marrow biopsy showed 70% cellularity, significant eosinophilia of the granulocytic series, moderate erythroid hypoplasia, and megakaryocytic hyperplasia. Almost 80% of the granulocytic series corresponded to eosinophils; however, it was reported negative to any neoplastic process. As no CD34, CD117, or blasts were observed, a neoplastic process was discarded (Fig. 4).

Figure 4 Hypocellular bone marrow with significant eosinophilia of the granulocytic series, moderate erythroid hypoplasia, and megakaryocytic hyperplasia.
The sequence 4Q12 (FIP1L1-PDGFA) was negative, as well as antinuclear antibodies (< 1:40).
Flow cytometry analysis showed the following values: CD3, 1418 cells/µl (rr 600-5000 cells/µl); CD4, 948.1 cells/µl (rr 400-3500 cells/µl); CD8, 344 cells/µl (rr 200-1900 cells/µl); CD56, 60 cells/µl; and CD19, 1468 cells/µl. No cardiac abnormalities, such as valves regurgitation, infiltrates, or intracardiac thrombus, were observed. Chest computed tomography scan revealed diffuse bilateral alveolitis (Fig. 5).
After analyzing blood tests, the hematologist confirmed the HES diagnosis. Treatment was started with intravenous prednisone 1 mg/kg per dose every 24 h in addition to inhaled budesonide. The infant responded favorably to treatment and discharged 6 days later. CBC before discharge showed 10,000 leukocytes with 6% eosinophils (600 cells). Steroid treatment continued at home, until clinical and laboratory remission.
Discussion
HES is a rare myeloproliferative disorder with hypereosinophilia (> 1500 cells/mm3) in the absence of another disease (such as allergies or infections) and with evidence of dysfunction at least in one organ1.
Chronic hypereosinophilia can lead to symptoms secondary to enzyme production by eosinophils or due to tissue infiltration. Different mechanisms can generate eosinophil overproduction, such as a stem cell mutation, which leads to the expression of a fused gene containing platelet-derived growth factor receptor (PDGF-R), alpha polypeptide platelet-derived growth factor receptor alpha (PDGFRA) with tyrosine kinase activity (FIP1L1-PDGFRA gene fusion), or interleukin-5 (IL-5) overproduction due to Th2 cell activity, with unusual phenotype or reordering clonal patterns of genes with Th2 cell receptors2.
The HES mainly affects adults between 20 and 50 years of age, with a 9:1 male-female ratio. The first case reported was a 30-year-old male with hypereosinophilia, high levels of IgE and IgM, and skin, and pulmonary and vascular affection. A national multicentric French study reported 21 cases, including a 5-year-old patient, being skin affection the most common initial symptom3-8.
This case report is significant because the patient fulfilled all the main criteria of HES, which is very rare in children, as no population-based registries are available. Although the actual incidence of HES is unknown, the review of literature for published de novo HES case reports using PubMed database from 1999 to June 2011 showed 141 cases (only 33 were children: 19 males and 14 females). The median age at diagnosis was 11 years (range 38 weeks-16 years), with a wide variety of symptoms, which the skin, lungs, and heart were the most frequently reported9.
During the first year of life, the present case most likely started to express skin affection attributed to atopic dermatitis. Since the first visit to the ER, the eosinophilia was evident in the CBC but still considered as related to atopy and other more common diagnoses. It was until the second admission when a further study for HES was performed, following the criteria of a total eosinophil count >1500 cell/mm3 in at least two different occasions within 1 month.
The National Institute of Health reported a case series with HES, in which the most common symptoms were fatigue (26%), cough (24%), fever (12%), dermatosis (12%), and retinal lesions (10%)7,10. Lefévre et al. analyzed 21 patients with the lymphoid variant and reported skin lesions in 18 patients including angioedema, urticaria, pruritus, and maculopapular rash; lymphadenopathies in 13 patients; personal history of asthma in five patients; eczema in six patients; and pulmonary affection, such as bronchitis, asthma, eosinophilic alveolitis, dyspnea, and pleural effusion in four patients. Gastrointestinal, neurological, or cardiovascular symptoms were less frequent; only one patient showed splenomegaly5.
Radiographic findings in the lymphoid variant of HES include pleural effusion and diffuse or focal infiltrates, observed in the present case. In the pulmonary biopsy, eosinophils can be found. Furthermore, infiltrate improves with steroid therapy, though a risk of pulmonary fibrosis as a late complication exists11. However, a lymphoid variant of HES (L-HES) was not concluded in this case because the diagnosis is based on detecting the most common aberrant phenotypes in L-HES (CD3-CD4+ and CD3+CD4-CD8-) by flow cytometry techniques5,12. Unfortunately, this information was not available for the present report.
In the HES, steroid response is often favorable, as observed with the patient. The suggested treatment is prednisone 0.5-1 mg/kg per day, while the second-line drugs are alpha interferon, mepolizumab, and cyclosporine. A close follow-up of the patients by a pediatrician or hematologist is essential, due to the risk of T-cell lymphoma in further years. The development of late lymphadenopathies must be studied to rule out this disease. Patients that develop lymphoma usually fail to respond to conventional chemotherapy treatment5,12,13.
This report allows to understanding HES in an infant whose symptoms may be present in other common pediatric illnesses such as atopic dermatitis, erysipelas, incomplete Kawasaki disease, or airway affections. Although rare, this pathology should be considered in a patient with common symptoms, and unusual evolution or poor treatment response and persistent hypereosinophilia. A complete assessment is vital to discard other significant complications, including cytogenetic disorders, and to perform a close follow-up due to the risk of lymphoma.
Ethical disclosures
Protection of human and animal subjects. The authors declare that no experiments were performed on humans or animals for this study.
Confidentiality of data. The authors declare that they have followed the protocols of their work center on the publication of patient data.
Right to privacy and informed consent. The authors have obtained the written informed consent of the patients or subjects mentioned in the article. The corresponding author is in possession of this document.










nueva página del texto (beta)